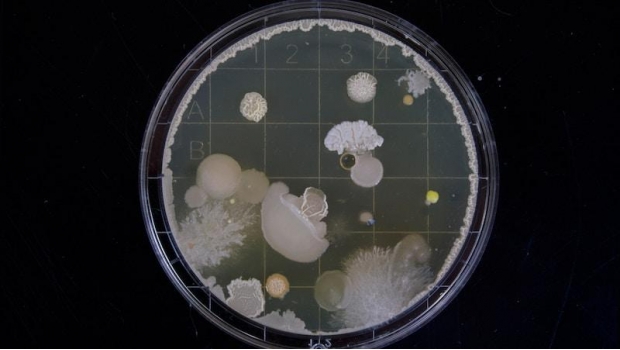

El mayor problema es que es resistente a los medicamentos disponibles.
La candida auris es un hongo recién descubierto que ataca principalmente a pacientes que han pasado un largo tiempo internados en un hospital y debido a que es resiste a los medicamentos anitimicóticos, se ha convertido en una amenaza mortal a nivel mundial.
A pesar de que han pasado casi 10 años desde que fue detectado por primera vez en Corea del Sur aún no logra desarrollarse un tratamiento eficaz que ayude a terminar con el hongo y prevenir consecuencias peores. Tras el primer caso, se detectaron otros en Sudáfrica, Kuwait y la India, y para 2016 alertó a las autoridades sanitarias con sus primeros brotes en América, lo que ha hecho que las instituciones médicas de todo el continente eleven la guardia para evitar nuevos casos.
Sobre la candida auris los Centros para el Control y Prevención de Enfermedades (CDC) de Estados Unidos, que recientemente ha presentado casos en Nueva York, Nueva Jersey e Illinois, han advertido que “representa una amenaza seria para la salud global”.
Al respecto, la especialista Constanza Taverna, del departamento de Micología del Instituto Dr. Carlos G. Malbrán en Argentina explicó que no se trata de un virus sino de un “patógeno oportunista”.
“En general afecta a pacientes inmunocomprometidos, pacientes que llevan muchos días de hospitalización, que llevan muchos días con antibióticos, que tienen catéteres”.
CONSTANZA TAVERNA
Mata, pero no muere
La candida auris ha tomado por sorpresa a una unidad neonatal en Venezuela y una sala de cuidados intensivos británica, entre otros pero uno de los casos más sonados fue el de un hombre de la tercera edad que llegó a un Hospital de Brooklyn para someterse una cirugía abdominal y al hacer los exámenes previos, se descubrió que estaba infectado por el germen así que los médicos lo aislaron rápidamente.
El paciente murió 90 días después en el hospital, pero tras hacer varias pruebas, el equipo del hospital encontró que toda la habitación estaba infestada del hongo y para erradicarlo fue necesaria maquinaria especial de limpieza e incluso retirar algunas baldosas de las paredes.
La candida auris en México
Actualmente no se tiene conocimiento de ningún paciente con el hongo en México, aunque se sabe que podría ser portado por alguna persona que haya estado en contacto con otro paciente sin desarrollar ninguna infección pues como ya dijimos, afecta principalmente a las personas con el sistema inmunológico debilitado.
Tampoco se ha tenido ningún pronunciamiento por parte de las autoridades correspondientes en nuestro país.
Con información de Infobae y Vía País